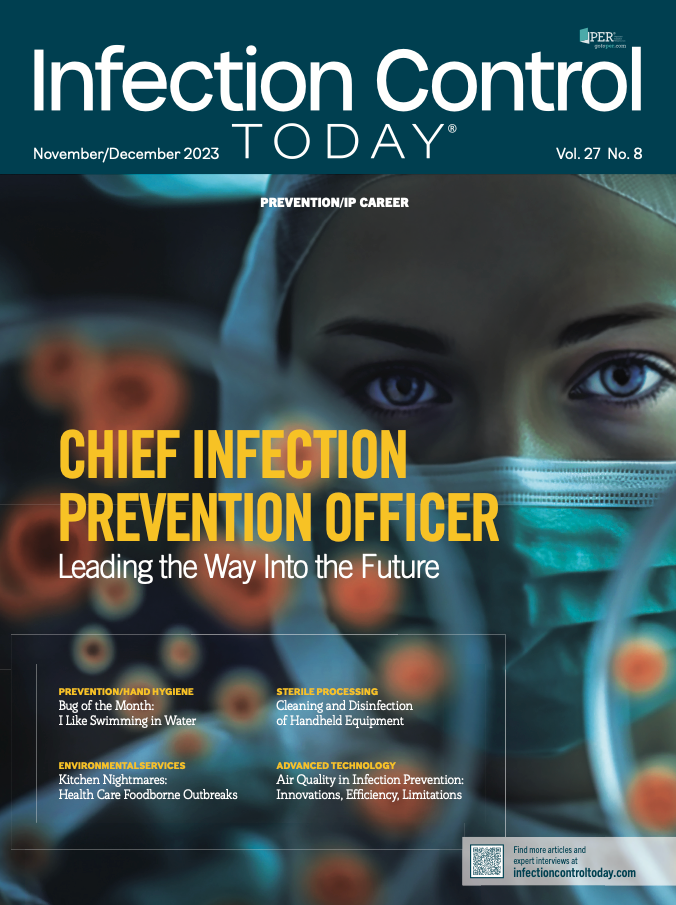

The Executive Director of the Certification Board of Infection Control and Epidemiology (CBIC) addresses the eligibility guidelines for the Certification in Infection Prevention and Control (CIC) examination. While designed for success, these guidelines are not requirements, ensuring inclusivity for candidates from diverse infection prevention backgrounds. The CBIC emphasizes readiness and offers support to prospective CIC candidates.
In my role as Executive Director of the Certification Board of Infection Control and Epidemiology, I am a regular reader of Infection Control Today®. I wanted to provide commentary on the feature posted on October 19, 2023: Infection Control Today analyzes the surprising findings from its recent informal survey on the minimum educational requirement for infection preventionists.
There is an excerpt in the article in which an individual respondent comments about not being able to apply for the Certification in Infection Prevention and Control (CIC). The examination has has eligibility guidelines put in place, but these are not requirements. The eligibility guidelines were developed by the CBIC Board of Directors and include the following:
·At least 1-year full-time employment
OR
·Two (2) years part-time employment
OR
·Completed 3,000 hours of infection prevention work experience earned during the previous three (3) years
The guidelines are designed to set a candidate up for success on the examination, but these are not requirements and do not preclude others from applying who are working in the field of infection prevention and control. We would encourage prospective candidates to review the examination content outline and candidate handbook before applying for the examination.
Thank you to the readers of Infection Control Today for participating in the educational requirements survey and I know many of you have worked hard to prepare for certification. CBIC wants you to be as ready as possible on exam day, and I am here as a resource (jdangles@CBIC.org) if you have any questions on CBIC certification.
Thank you,
Jessica Dangles, MBA, MS, PMP
Executive Director
Certification Board of Infection Control and Epidemiology
jdangles@CBIC.org
Stay prepared and protected with Infection Control Today's newsletter, delivering essential updates, best practices, and expert insights for infection preventionists.